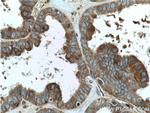
FMN2 Antibody in Immunohistochemistry (Paraffin) (IHC (P))
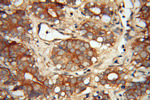
FMN2 Antibody in Immunohistochemistry (Paraffin) (IHC (P))

Search
Proteintech
FMN2 Polyclonal Antibody
{{$productOrderCtrl.translations['antibody.pdp.commerceCard.promotion.promotions']}}
{{$productOrderCtrl.translations['antibody.pdp.commerceCard.promotion.viewpromo']}}
{{$productOrderCtrl.translations['antibody.pdp.commerceCard.promotion.promocode']}}: {{promo.promoCode}} {{promo.promoTitle}} {{promo.promoDescription}}. {{$productOrderCtrl.translations['antibody.pdp.commerceCard.promotion.learnmore']}}
产品信息
11259-1-AP
种属反应
已发表种属
宿主/亚型
分类
类型
抗原
偶联物
形式
浓度
规格
纯化类型
保存液
内含物
保存条件
运输条件
产品详细信息
Immunogen sequence: GQADGFGLD ILPKLKDVKS SDNSRSLLSY IVSYYLRNFD EDAGKEQCLF PLPEPQDLFQ ASQMKFEDFQ KDLRKLKKDL KACEVEAGKV YQVSSKEHMQ PFKENMEQFI IQAKIDQEAE ENSLTETHKC FLETTAYFFM KPKLGEKEVS PNAFFSIWHE FSSDFKDFWK KENKLLLQER VKEAEEVCRQ KKGKSLYKIK PRHDSGIKAK ISMKT (1509-1722 aa encoded by BC014364 )
靶标信息
FMN2, a novel formin homology protein of the cappuccino subfamily, is highly conserved between evolutionarily diverse vertebrates. FMN2 bears a high degree of similarity to formin-1 which is the founding member of formin homology proteins. FMN2 plays a crucial role in maintenance of the meiotic spindle. The protein is widely expressed in human fetal brain, adult whole brain, hypothalamus, retina, pancreatic islet and germinal-center B cells. Pathological role of the protein is identified in various tumors like parathyloid tumor, glioblastoma, retinoblastoma and chondrosarcoma. FMN2 mutations are often a cause of unexplained infertility in women. The gene encoding for human FMN2 is localized in the chromosomal region 1q43.
仅用于科研。不用于诊断过程。未经明确授权不得转售。
生物信息学
蛋白别名: Formin-2; RP11-90L13.1; unnamed protein product
基因别名: AU024104; FMN2
UniProt ID: (Human) Q9NZ56, (Mouse) Q9JL04
Entrez Gene ID: (Human) 56776, (Mouse) 54418